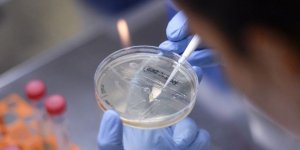
Covıd- 19 aşısı için Noel müjdesi

- KTMMOB, resepsiyon düzenledi
- “Ekilebilir tarım arazilerinin her geçen gün azalması endişe verici boyutta”
- “Sessiz Çığlıklar” karma resim ve heykel sergisi Girne’de açılacak
- “Liyakatsiz atama ve keyfi görevlendirmeler yapılıyor”
- Mesarya Belediyesi Aslanköy’de çevre düzenleme çalışmalarını sürdürüyor
- Erhürman - Holguin görüşmesi başladı
- "Çalışanları köle yapmanıza izin vermeyeceğiz"
- Müsteşar Cahitoğlu’ndan ses örneği alındı
- “Mavi’nin 16 Yıllık Yolculuğu” sergisi pazartesi Mağusa’da…
- BM: Ukrayna'daki savaşta ateşkese yakın olduğumuzu hissetmiyoruz